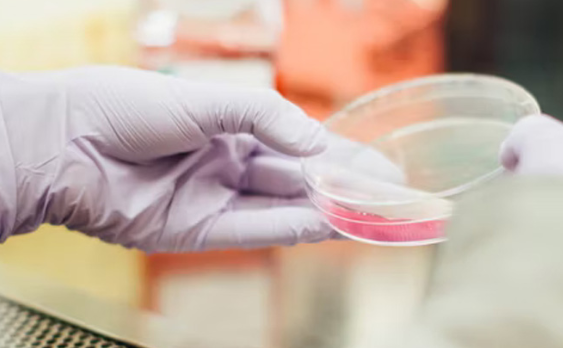

中宣部、国家卫生健康委联合发布2022年“最美医生”先进事迹
新华社北京8月17日电 为深入学习贯彻习近平总书记关于卫生健康工作的重要指示批示精神,大力弘扬伟大建党精神、伟大抗疫精神,激励广大医疗卫生工作者为守护人民健康不懈奋斗,在第五个“中国医师节”即将到来之际,中宣部、国家卫生健康委向全社会公开发布2022年“最美医生”先进事迹。
新华社北京8月17日电 为深入学习贯彻习近平总书记关于卫生健康工作的重要指示批示精神,大力弘扬伟大建党精神、伟大抗疫精神,激励广大医疗卫生工作者为守护人民健康不懈奋斗,在第五个“中国医师节”即将到来之际,中宣部、国家卫生健康委向全社会公开发布2022年“最美医生”先进事迹。
丁仁彧、马文义、许润三、孙宁、张静、周行涛、胡敏华、高琪、管向东、潘凤等10名个人和抗击新冠肺炎疫情国家流调专家队光荣入选。他们有的悬壶济世,为中医药事业奉献一生;有的数次出征,奋战在抗击新冠肺炎疫情一线;有的潜心钻研,为消除疟疾作出重要贡献;有的躬身前行,呵护儿童青少年视力健康;有的润物无声,坚守数十年为患者点燃心灯;有的扎根边疆、守护高原村寨群众健康;还有的激扬青春,在追梦奋斗中展现青年医者担当……他们坚持人民至上、生命至上,积极投身健康中国建设,矢志不渝维护人民健康,生动展现了党领导卫生健康事业的奋斗历程和光辉成就,深刻诠释了“敬佑生命、救死扶伤、甘于奉献、大爱无疆”的崇高精神。
许多医疗卫生工作者表示,要以“最美医生”为榜样,恪守医德医风医道,不断提升业务能力,切实担当作为,努力为人民群众提供更加优质高效的健康服务,用实际行动迎接党的二十大胜利召开。
咨询
- 364
- 点赞
- 复制链接
- 举报